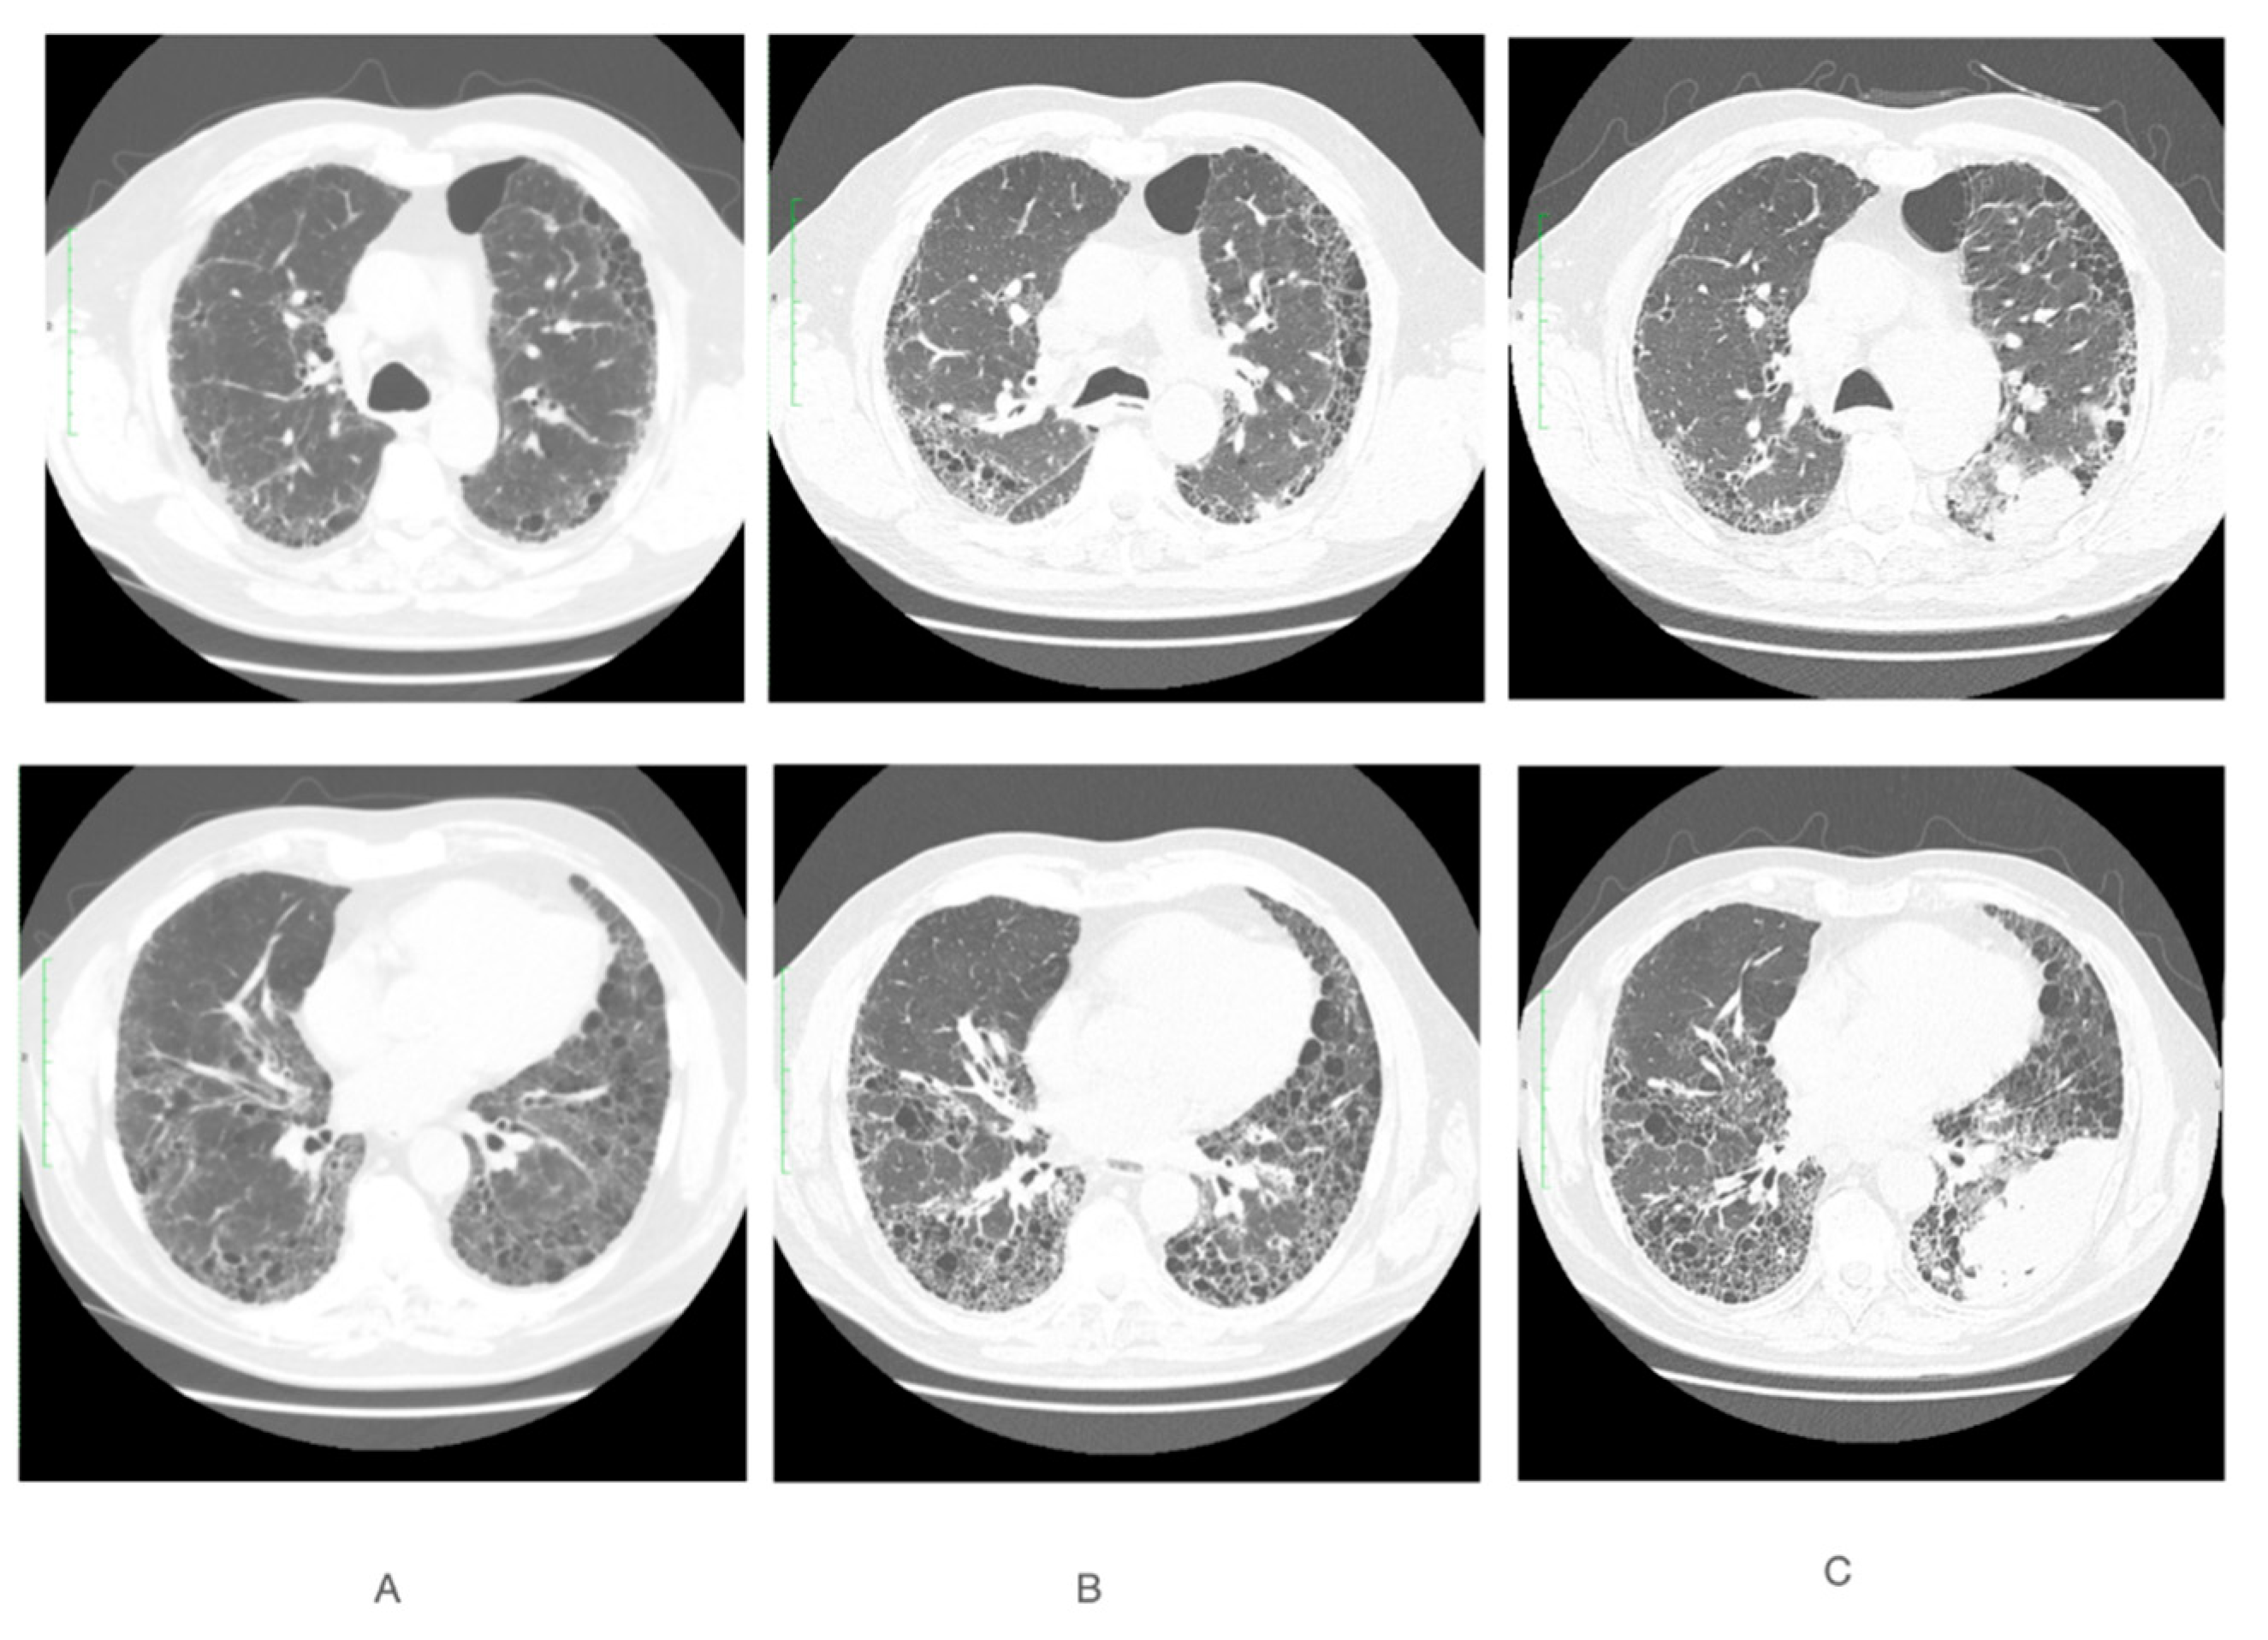
Curroncol 29 00401 g001 Curroncol 29 00401 g001

Small Cell Lung Cancer in the Course of Idiopathic Pulmonary Fibrosis—Case Report and Literature Review
Abstract
1. Introduction
2. Case Report
3. Discussion
Author Contributions
Funding
Institutional Review Board Statement
Informed Consent Statement
Data Availability Statement
Conflicts of Interest
References
- Raghu, G.; Collard, H.R.; Egan, J.J.; Martinez, F.J.; Behr, J.; Brown, K.K.; Colby, T.V.; Cordier, J.F.; Flaherty, K.R.; Lasky, J.A.; et al. An official ATS/ERS/JRS/ALAT statement: Idiopathic pulmonary fibrosis: Evidence-based guidelines for diagnosis and management. Am. J. Respir. Crit. Care Med. 2011, 183, 788–824. [Google Scholar] [CrossRef]
- Martinez, F.J.; Collard, H.R.; Pardo, A.; Raghu, G.; Richeldi, L.; Selman, M.; Swigris, J.J.; Taniguchi, H.; Wells, A.U. Idiopathic pulmonary fibrosis. Nat. Rev. Dis. Primers 2017, 3, 17074. [Google Scholar] [CrossRef]
- King, C.S.; Nathan, S.D. Idiopathic pulmonary fibrosis: Effects and optimal management of comorbidities. Lancet Respir. Med. 2017, 5, 72–84. [Google Scholar] [CrossRef]
- Brown, S.W.; Dobelle, M.; Padilla, M.; Agovino, M.; Wisnivesky, J.P.; Hashim, D.; Boffetta, P. Idiopathic Pulmonary Fibrosis and Lung Cancer. A Systematic Review and Meta-analysis. Ann. Am. Thorac. Soc. 2019, 16, 1041–1051. [Google Scholar] [CrossRef]
- Lee, T.; Park, J.Y.; Lee, H.Y.; Cho, Y.J.; Yoon, H.I.; Lee, J.H.; Jheon, S.; Lee, C.T.; Park, J.S. Lung cancer in patients with idiopathic pulmonary fibrosis: Clinical characteristics and impact on survival. Respir. Med. 2014, 108, 1549–1555. [Google Scholar] [CrossRef]
- Jett, J.R.; Schild, S.E.; Kesler, K.A.; Kalemkerian, G.P. Treatment of small cell lung cancer: Diagnosis and management of lung cancer, 3rd ed: American College of Chest Physicians evidence-based clinical practice guidelines. Chest 2013, 143, e400S–e419S. [Google Scholar] [CrossRef]
- Kreuter, M.; Ehlers-Tenenbaum, S.; Schaaf, M.; Oltmanns, U.; Palmowski, K.; Hoffmann, H.; Schnabel, P.A.; Heußel, C.P.; Puderbach, M.; Herth, F.J.; et al. Treatment and outcome of lung cancer in idiopathic interstitial pneumonias. Sarcoidosis Vasc. Diffus. Lung Dis. 2015, 31, 266–274. [Google Scholar]
- Tzouvelekis, A.; Gomatou, G.; Bouros, E.; Trigidou, R.; Tzilas, V.; Bouros, D. Common Pathogenic Mechanisms Between Idiopathic Pulmonary Fibrosis and Lung Cancer. Chest 2019, 156, 383–391. [Google Scholar] [CrossRef]
- Tomassetti, S.; Gurioli, C.; Ryu, J.H.; Decker, P.A.; Ravaglia, C.; Tantalocco, P.; Buccioli, M.; Piciucchi, S.; Sverzellati, N.; Dubini, A. The impact of lung cancer on survival of idiopathic pulmonary fibrosis. Chest 2015, 147, 157–164. [Google Scholar] [CrossRef]
- Vancheri, C.; Failla, M.; Crimi, N.; Raghu, G. Idiopathic pulmonary fibrosis: A disease with similarities and links to cancer biology. Eur. Respir. J. 2010, 35, 496–504. [Google Scholar] [CrossRef]
- Vancheri, C. Idiopathic pulmonary fibrosis and cancer: Do they really look similar? BMC Med. 2015, 13, 220. [Google Scholar] [CrossRef] [PubMed]
- Wang, Y.; Kuan, P.J.; Xing, C.; Cronkhite, J.T.; Torres, F.; Rosenblatt, R.L.; DiMaio, J.M.; Kinch, L.N.; Grishin, N.V.; Garcia, C.K. Genetic defects in surfactant protein A2 are associated with pulmonary fibrosis and lung cancer. Am. J. Hum. Genet. 2009, 84, 52–59. [Google Scholar] [CrossRef] [PubMed]
- van Moorsel, C.H.; Ten Klooster, L.; van Oosterhout, M.F.; de Jong, P.A.; Adams, H.; van Es, H.W.; Ruven, H.J.; van der Vis, J.J.; Grutters, J.C. SFTPA2 Mutations in Familial and Sporadic Idiopathic Interstitial Pneumonia. Am. J. Respir. Crit. Care Med. 2015, 192, 1249–1252. [Google Scholar] [CrossRef]
- Nathan, N.; Giraud, V.; Picard, C.; Nunes, H.; Dastot-Le Moal, F.; Copin, B.; Galeron, L.; De Ligniville, A.; Kuziner, N.; Reynaud-Gaubert, M. Germline SFTPA1 mutation in familial idiopathic interstitial pneumonia and lung cancer. Hum. Mol. Genet. 2016, 25, 1457–1467. [Google Scholar] [CrossRef] [PubMed]
- Collard, H.R.; Ryerson, C.J.; Corte, T.J.; Jenkins, G.; Kondoh, Y.; Lederer, D.J.; Lee, J.S.; Maher, T.M.; Wells, A.U.; Antoniou, K.M. Acute Exacerbation of Idiopathic Pulmonary Fibrosis. An International Working Group Report. Am. J. Respir. Crit. Care Med. 2016, 194, 265–275. [Google Scholar] [CrossRef]
- Kim, E.J.; Kim, S.R.; Jin Gang, S.; Park, S.Y.; Han, Y.M.; Lee, Y.C. Tonsillar metastasis of small cell lung cancer in a patient with idiopathic pulmonary fibrosis: A case report. Medicine 2015, 94, e565. [Google Scholar] [CrossRef]
- Yamamoto, Y.; Yano, Y.; Kuge, T.; Okabe, F.; Ishijima, M.; Uenami, T.; Kanazu, M.; Akazawa, Y.; Yamaguchi, T.; Mori, M. Safety and effectiveness of pirfenidone combined with carboplatin-based chemotherapy in patients with idiopathic pulmonary fibrosis and non-small cell lung cancer: A retrospective cohort study. Thorac. Cancer 2020, 11, 3317–3325. [Google Scholar] [CrossRef]
- Miyazaki, K.; Satoh, H.; Kurishima, K.; Nakamura, R.; Ishikawa, H.; Kagohashi, K.; Hizawa, N. Interstitial lung disease in patients with small cell lung cancer. Med. Oncol. 2010, 27, 763–767. [Google Scholar] [CrossRef]
- Togashi, Y.; Masago, K.; Handa, T.; Tanizawa, K.; Okuda, C.; Sakamori, Y.; Nagai, H.; Kim, Y.H.; Mishima, M. Prognostic significance of preexisting interstitial lung disease in Japanese patients with small-cell lung cancer. Clin. Lung Cancer 2012, 13, 304–311. [Google Scholar] [CrossRef][Green Version]
- JafariNezhad, A.; YektaKooshali, M.H. Lung cancer in idiopathic pulmonary fibrosis: A systematic review and meta-analysis. PLoS ONE 2018, 13, e0202360. [Google Scholar] [CrossRef]
- Yoshida, T.; Yoh, K.; Goto, K.; Niho, S.; Umemura, S.; Ohmatsu, H.; Ohe, Y. Safety and efficacy of platinum agents plus etoposide for patients with small cell lung cancer with interstitial lung disease. Anticancer Res. 2013, 33, 1175–1179. [Google Scholar] [PubMed]
- Minegishi, Y.; Kuribayashi, H.; Kitamura, K.; Mizutani, H.; Kosaihira, S.; Okano, T.; Seike, M.; Azuma, A.; Yoshimura, A.; Kudoh, S.; et al. The feasibility study of Carboplatin plus Etoposide for advanced small cell lung cancer with idiopathic interstitial pneumonias. J. Thorac. Oncol. 2011, 6, 801–807. [Google Scholar] [CrossRef] [PubMed]
- Kashiwabara, K.; Semba, H.; Fujii, S.; Tsumura, S.; Aoki, R. Difference in benefit of chemotherapy between small cell lung cancer patients with interstitial pneumonia and patients with non-small cell lung cancer. Anticancer Res. 2015, 35, 1065–1071. [Google Scholar] [PubMed]
- Gottfried, M.; Bennouna, J.; Bondarenko, I.; Douillard, J.Y.; Heigener, D.F.; Krzakowski, M.; Mellemgaard, A.; Novello, S.; Orlov, S.; Summers, Y.; et al. Efficacy and Safety of Nintedanib Plus Docetaxel in Patients with Advanced Lung Adenocarcinoma: Complementary and Exploratory Analyses of the Phase III LUME-Lung 1 Study. Target Oncol. 2017, 12, 475–485. [Google Scholar] [CrossRef] [PubMed]
- Dhillon, S. Nintedanib: A Review of Its Use as Second-Line Treatment in Adults with Advanced Non-Small Cell Lung Cancer of Adenocarcinoma Histology. Target Oncol. 2015, 10, 303–310. [Google Scholar] [CrossRef] [PubMed]
- Dabholkar, S.; Gao, B.; Chuong, B. Nintedanib-A case of treating concurrent idiopathic pulmonary fibrosis and non-small cell lung cancer. Respirol. Case Rep. 2022, 10, e0902. [Google Scholar] [CrossRef]
- Fukunaga, K.; Yokoe, S.; Kawashima, S.; Uchida, Y.; Nakagawa, H.; Nakano, Y. Nintedanib prevented fibrosis progression and lung cancer growth in idiopathic pulmonary fibrosis. Respirol. Case Rep. 2018, 6, e00363, indexed in Pubmed: 30237884.4. [Google Scholar] [CrossRef]
- Kai, Y.; Matsuda, M.; Fukuoka, A.; Hontsu, S.; Yamauchi, M.; Yoshikawa, M.; Muro, S. Remarkable response of non-small cell lung cancer to nintedanib treatment in a patient with idiopathic pulmonary fibrosis. Thorac. Cancer 2021, 12, 1457–1460. [Google Scholar] [CrossRef]
- Shiratori, T.; Tanaka, H.; Tabe, C.; Tsuchiya, J.; Ishioka, Y.; Itoga, M.; Taima, K.; Takanashi, S.; Tasaka, S. Effect of nintedanib on non-small cell lung cancer in a patient with idiopathic pulmonary fibrosis: A case report and literature review. Thorac. Cancer 2020, 11, 1720–1723. [Google Scholar] [CrossRef]
- Mathieu, L.; Shah, S.; Pai-Scherf, L.; Larkins, E.; Vallejo, J.; Li, X.; Rodriguez, L.; Mishra-Kalyani, P.; Goldberg, K.B.; Kluetz, P.G.; et al. FDA Approval Summary: Atezolizumab and Durvalumab in Combination with Platinum-Based Chemotherapy in Extensive Stage Small Cell Lung Cancer. Oncologist 2021, 26, 433–438. [Google Scholar] [CrossRef]
- Ide, M.; Tanaka, K.; Sunami, S.; Asoh, T.; Maeyama, T.; Tsuruta, N.; Nakanishi, Y.; Okamoto, I. Durable response to nivolumab in a lung adenocarcinoma patient with idiopathic pulmonary fibrosis. Thorac. Cancer 2018, 9, 1519–1521. [Google Scholar] [CrossRef] [PubMed]
- Yamakawa, H.; Oba, T.; Ohta, H.; Tsukahara, Y.; Kida, G.; Tsumiyama, E.; Nishizawa, T.; Kawabe, R.; Sato, S.; Akasaka, K.; et al. Nintedanib allows retreatment with atezolizumab of combined non-small cell lung cancer/idiopathic pulmonary fibrosis after atezolizumab-induced pneumonitis: A case report. BMC Pulm. Med. 2019, 19, 156. [Google Scholar] [CrossRef] [PubMed]
- Zhang, X.; Li, W.; Li, C.; Zhang, J.; Su, Z. Chemotherapy in idiopathic pulmonary fibrosis and small-cell lung cancer with poor lung function. BMC Pulm. Med. 2021, 21, 122. [Google Scholar] [CrossRef] [PubMed]

Publisher’s Note: MDPI stays neutral with regard to jurisdictional claims in published maps and institutional affiliations. |
© 2022 by the authors. Licensee MDPI, Basel, Switzerland. This article is an open access article distributed under the terms and conditions of the Creative Commons Attribution (CC BY) license (https://creativecommons.org/licenses/by/4.0/).
Share and Cite
Grodkiewicz, M.; Koziel, P.; Chmielewska, I.; Korbel, M.A.; Milanowski, J. Small Cell Lung Cancer in the Course of Idiopathic Pulmonary Fibrosis—Case Report and Literature Review. Curr. Oncol. 2022, 29, 5077-5083. https://doi.org/10.3390/curroncol29070401
Grodkiewicz M, Koziel P, Chmielewska I, Korbel MA, Milanowski J. Small Cell Lung Cancer in the Course of Idiopathic Pulmonary Fibrosis—Case Report and Literature Review. Current Oncology. 2022; 29(7):5077-5083. https://doi.org/10.3390/curroncol29070401
Chicago/Turabian StyleGrodkiewicz, Maria, Pawel Koziel, Izabela Chmielewska, Marta Adamczyk Korbel, and Janusz Milanowski. 2022. "Small Cell Lung Cancer in the Course of Idiopathic Pulmonary Fibrosis—Case Report and Literature Review" Current Oncology 29, no. 7: 5077-5083. https://doi.org/10.3390/curroncol29070401
APA StyleGrodkiewicz, M., Koziel, P., Chmielewska, I., Korbel, M. A., & Milanowski, J. (2022). Small Cell Lung Cancer in the Course of Idiopathic Pulmonary Fibrosis—Case Report and Literature Review. Current Oncology, 29(7), 5077-5083. https://doi.org/10.3390/curroncol29070401




